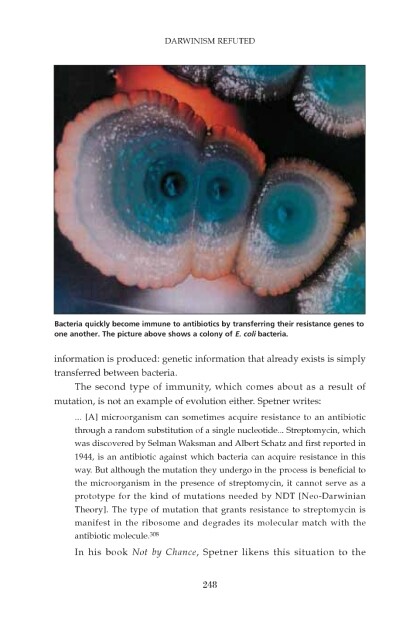

Darwinism Refuted by HARUN YAHYA (best book club books of all time txt) 📖
Download in Format:
- Author: HARUN YAHYA
Book online «Darwinism Refuted by HARUN YAHYA (best book club books of all time txt) 📖». Author HARUN YAHYA

Publication Date: 06-25-2011
All Rights Reserved
Free ebook «Darwinism Refuted by HARUN YAHYA (best book club books of all time txt) 📖» - read online now
Similar e-books:
Comments (0)